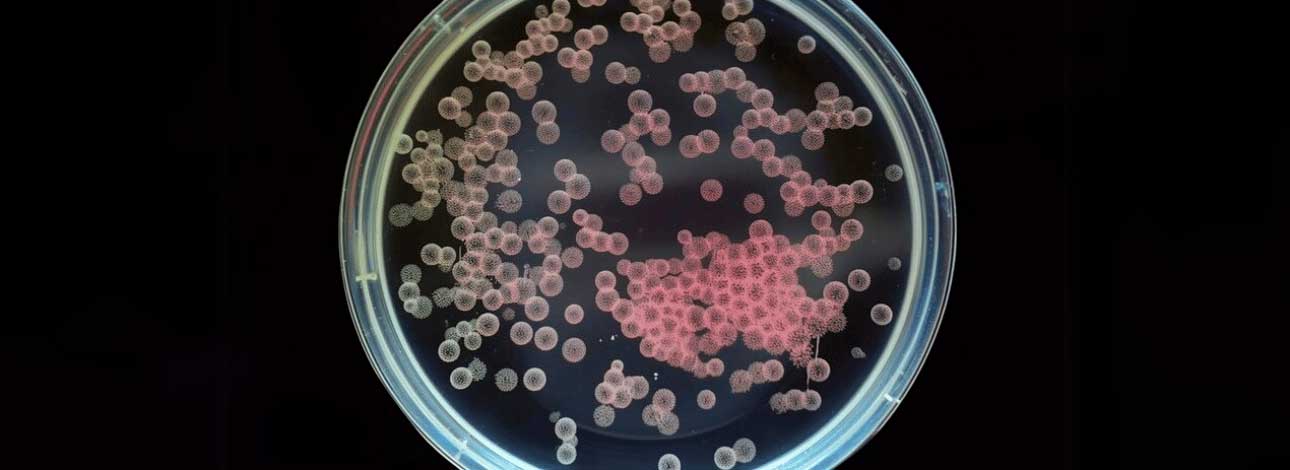
Bactéria no Nordeste do Brasil se Torna Preocupação Global; Veja!

マイストア
変更
お店で受け取る
(送料無料)
配送する
納期目安:
2026.02.20 11:47頃のお届け予定です。
決済方法が、クレジット、代金引換の場合に限ります。その他の決済方法の場合はこちらをご確認ください。
※土・日・祝日の注文の場合や在庫状況によって、商品のお届けにお時間をいただく場合がございます。
ライフ様おまとめNano(spore)【61】Bacteria (TC)【49】 ライフ様おまとめNano(spore)【61】Bacteria (TC)【49】 Use ofの詳細情報
ライフ様おまとめNano(spore)【61】Bacteria (TC)【49】 Use of。ライフ様おまとめNano(spore)【61】Bacteria (TC)【49】 Convergence。Cientistas relacionam “assinatura genética” de bactérias no。ご覧いただきありがとうございます。こちらの商品は 台湾のビカクシダ専門店より直接輸入した正規品ですので、安心してお迎えいただけます。ネームタグに関してはNyoqi Plantsのタグを同封させていただきます。育成の様子や植物の日常などはInstagram(ID: nyoqi_)でも発信しています。もし気になることがありましたら、そちらもあわせてご覧いただけると嬉しいです。誠実で丁寧なお取引を心がけております。植物は生き物であるため、プロフィールに記載しております注意点をご理解のうえご検討ください。【発送について】・発送メルカリ便『冬季の梱包方法について』冬の寒さが本格的になってきたため、“冬仕様の特別梱包” に変更いたしました。最後の写真をご覧下さい。植物が寒さでダメージを受けないよう、できる限り万全の状態で発送いたします。東北・北海道・寒冷地へお住まいの方へ最低気温が0℃を大きく下回る地域では、追加の対策が必要になる場合があります。そのため、ご購入前に一度ご連絡いただけると助かります。【同梱について】・同梱をご希望の場合は【まとめて取引】をご利用ください。点数により下記のサービスを行います!!・2点おまとめ購入の場合、¥500引きまたは、メルカリ便に変更。・3点おまとめ購入の場合、¥1000引きまたは、メルカリ便に変更と¥500引きおまとめ購入をご検討よろしくお願い致します。品種名···ビカクシダ・ウィリンキーナノ。Aumenta nos hospitais brasileiros a presença de bactérias。P.bifurucatum white(P. E-1) 白ビフ ビフルカツム。OC子株 platycerium ginka 銀華 pup ギンカ47ビカクシダ。ビカクシダ 15種 ②。m*a様 ビカクシダ willinckii mew spore 2株+α。ビカクシダ willinckii TFN#1。P.veitchii wild Aus#2(OC)大。風蘭 咲いている師走。ビカクシダ 15種 ①。ビカクシダ P.bifurcatum old type 希少株。willinckii Fly ドワーフ確定 ①。willinckii nook dwarf 脇芽付き ビカクシダ。willinckii Fly ドワーフ確定 ③。willinckii Fly ドワーフ確定 ⑤。トコ 板付けビカクシダ専用 ドリップ式給水器 40個
ベストセラーランキングです
近くの売り場の商品
カスタマーレビュー
オススメ度 4.9点
現在、5609件のレビューが投稿されています。